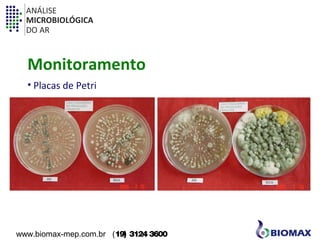
ANÁLISE 
MICROBIOLÓGICA 
DO AR 
Monitoramento 
• Placas de Petri 
www.biomax-mep.com.br (19) 3124 3600

O documento discute a análise microbiológica do ar, incluindo a importância de monitorar microrganismos no ar, especialmente em ambientes como hospitais e indústrias. Também descreve métodos como o Surface Air System para amostragem do ar e o uso de placas de Petri e meios de cultura para contagem e identificação de microrganismos no laboratório.